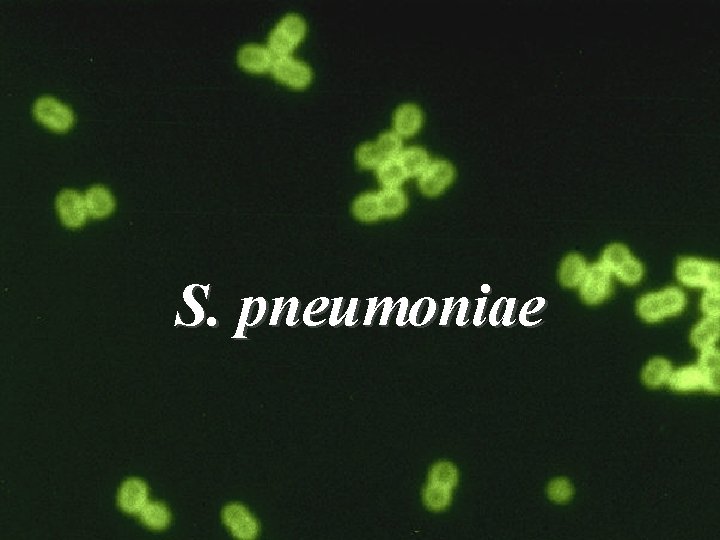
S. pneumoniae 3

Streptococcus pneumoniae Staphylococci Gram positive cocci Lecture 38

- Slides: 34
Streptococcus pneumoniae Staphylococci (Gram positive cocci) Lecture 38 Faculty: Dr. Alvin Fox 1
KEYWORDS • − − − − • Staphylococcus aureus S. pneumoniae - coagulase (+) diplococci - MRSA (methicillin resistant S. aureus) Pneumococcus - opportunistic diseases autolysin - food poisoning/enterotoxins bile solubility test - toxic shock syndrome/toxic shock toxin optochin susceptibility - exfoliative toxin/scalded skin syndrome capsule - α, β, γ and δ cytotoxins - leucocidin Quellung reaction - lipase Polyvalent vaccine - hyaluronidase - protein A - coagulase (–) - Staphylococcus epidermidis 2 - Staphylococcus saprophyticus
S. pneumoniae 3
S. pneumoniae • leading cause of pneumonia – – – • • • particularly young and old member normal flora, nasopharynx replication and spread after damage to upper respiratory tract (e. g. after the flu) bacteremia meningitis middle ear infections (otitis media) - children 4
S. pneumoniae • α hemolytic • pneumolysin – degrades red blood cells under aerobic conditions • grows well on sheep blood agar • no group antigen 5
Diagnosis - spinal fluid • direct Gram staining • detection of capsular antigen 6
Autolysis – identification after growth autolysin lipoteichoic acid Bile teichoic acid -choline peptidoglycan autolysin Cell membrane 7
C polysaccharide • Teichoic acid (C polysaccharide) – precipitates in serum – binds C-reactive protein 8
Identification optochin resistant optochin sensitive 9
Capsule • prominent – virulent strains • anti-phagocytic • carbohydrate antigens – highly variable among strains – numerous serotypes 10
Capsular vaccine • Immunity – serotype specific – to eradicate the organism in normal flora • Vaccine – a few major serotypes (polyvalent) • Vaccination or the susceptible population – young children – elderly • Immunization – major serotypes susceptible to change – population monitoring essential 11
Quellung reaction • using antisera • capsule "fixed" • visible microscopically 12
Pathogenesis • Teichoic acid – complement activation – large numbers of inflammatory cells at infection site 13
Therapy • S. pneumoniae – most strains susceptible to penicillin – resistance is common 14
STAPHYLOCOCCI • • • Gram positive Facultative anaerobes Grape like-clusters Catalase positive Major components of normal flora - skin - nares 15
Staphylococcus aureus 16
One of commonest opportunistic infections, both hospital and community acquired: acquired • pneumonia • osteomyelitis • septic arthritis • bacteremia • endocarditis • abscesses/boils • other skin infections 17
Antibiotic therapy • Resistance to penicillin – penicillinase • Resistance to methicillin ‾ modified penicillin binding protein ‾ methicillin resistant S. aureus (MRSA) • Vancomycin • current drug of choice • resistance observed but uncommon at this time 18
Hospital infection control • MRSA now such a problem – monitoring by PCR of nasal swabs – eradication • antibiotics • whole body antisepsis 19
Food poisoning • not an infection • food contaminated by humans – growth of bacteria – production of enterotoxin • onset and recovery both occur within few hours 20
Food poisoning • • Vomiting nausea diarrhea abdominal pain 21
Toxic shock syndrome. 22
Toxic shock syndrome • fever • rash • desquamation • vomiting • diarrhea 23
Toxic shock syndrome • Toxic shock toxin - Dissemination • Organism – no dissemination 24
S. aureus • babies – scalded skin syndrome • exfoliatin 25
Lytic exotoxins: • • α toxin β toxin (sphingomyelinase C) γ toxin δ toxins – detergent-like • leucocidins 26
Protein A inhibits phagocytosis Fc receptor immunoglobulin PHAGOCYTE Protein A BACTERIUM 27
Spread • tissue-degrading enzymes – lipase – hyaluronidase 28
Identification • Sheep blood agar – β hemolytic – yellow pigmented (aureus) • mannitol fermentation • coagulase-positive • phage-typing, rarely performed 29
Staphylococcus epidermidis • major member, skin flora • opportunistic infection - less common than S. aureus • nosomial infections - shunts, catheters • artificial heart valves/joints 30
Identification • Sheep blood agar – non-hemolytic – Non-pigmented • Does not ferment mannitol • Coagulase negative 31
Several other coagulase negative staphylococcal species • common on human skin • some species cause opportunistic infection 32
Staphylococcus saprophyticus • urinary tract infections • this coagulase-negative species (and others) – not usually differentiated from S. epidermidis 33
Summary Figure (Identification Scheme) Note: S. viridans is ALPHA hemolytic and negative for all the tests below GRAM POSITIVE COCCI Catalase + Staphylococcus (Clusters) Coagulase + S. aureus Beta hemolytic mannitol yellow - S. epidermidis Non-hemolytic mannitol white - Streptococcus (pairs & chains) Hemolysis/Test BETA: Bacitracin + S. pyogenes (group A) CAMP/ Hippurate + S. agalactiae (group B) ALPHA: Optochin /Bile Solubility + S. pneumoniae GAMMA OR ALPHA: Bile Esculin + 6. 5% Na. Cl Enterococcus + Bile Esculin + 6. 5% Na. Cl Group D Non-Enterococcus Group D - 34